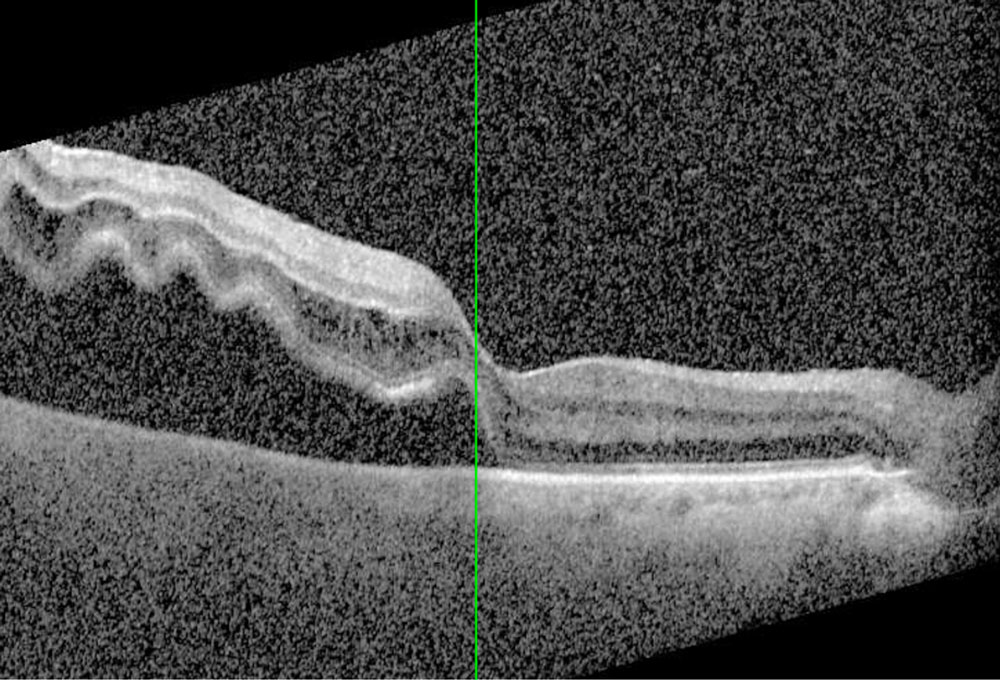

Décollement de rétine : urgence ophtalmologique
Qu’est-ce qu’un décollement de rétine ?
La rétine est une fine membrane située au fond de l’œil, qui capte la lumière et permet de voir.
Un décollement de rétine survient lorsqu’elle se sépare de son support (l’épithélium pigmentaire rétinien).
Sans contact avec ce tissu nourricier, les cellules rétiniennes ne sont plus irriguées correctement et risquent de mourir, entraînant une perte définitive de la vision.
C’est une urgence médicale absolue : plus le traitement est rapide, plus les chances de récupération visuelle sont élevées.
Symptômes d’alerte
Un décollement de rétine n’est jamais douloureux. Les signes sont visuels :
- Phosphènes : éclairs lumineux, surtout dans l’obscurité.
- Myodésopsies : apparition soudaine de « mouches volantes » ou filaments dans le champ visuel.
- Voile noir progressif** : impression qu’un rideau tombe sur une partie du champ visuel.
- Baisse de vision partielle ou totale
👉 Devant ces symptômes, il faut consulter en urgence un ophtalmologiste.
Facteurs de risque
- Forte myopie.
- Antécédent de décollement de rétine dans l’autre œil.
- Chirurgie intraoculaire (notamment cataracte).
- Traumatisme oculaire.
- Dégénérescences périphériques de la rétine (zones fragiles).
- Antécédents familiaux.
Diagnostic
Le diagnostic se fait lors d’un examen du fond d’œil.
L’ophtalmologiste visualise directement la zone décollée et recherche une déchirure ou une déhiscence rétinienne.
Traitements du décollement de rétine
La seule solution est chirurgicale. Le type d’intervention dépend de l’importance du décollement :
1. Laser ou cryothérapie (préventif ou très limité)
Si la rétine présente une petite déchirure mais pas encore de décollement complet, un laser ou une cryothérapie (congélation) peut « souder » la rétine et éviter la progression.
2. Chirurgie classique (scléral)
Une bandelette en silicone est posée à la surface de l’œil pour rapprocher la paroi et la rétine décollée.
3. Vitrectomie
Technique la plus courante : le chirurgien retire le vitré (gel de l’œil) qui tire sur la rétine, puis injecte un gaz ou de l’huile de silicone pour la plaquer contre la paroi.
Le gaz se résorbe en quelques semaines, l’huile doit parfois être retirée lors d’une 2e intervention.
Suites et pronostic
- Après chirurgie, la vision met plusieurs semaines à se stabiliser.
- Le pronostic dépend surtout de l’atteinte de la macula (zone centrale de la vision) : si elle est décollée, la récupération sera limitée.
- Un suivi régulier est indispensable, car le risque de récidive existe.
Prévention
- Surveillance régulière en cas de forte myopie ou d’antécédent familial.
- Examen urgent en cas de symptômes d’alerte.
- Traitement préventif au laser des zones fragiles détectées au fond d’œil.
FAQ – Décollement de rétine
1. Le décollement de rétine fait-il mal ?
Non, il est indolore. Les signes sont uniquement visuels (éclairs, mouches, voile noir).
2. Peut-on prévenir un décollement de rétine ?
On peut traiter préventivement certaines déchirures au laser, mais il n’existe pas de prévention absolue.
3. Quelle est l’urgence de l’opération ?
Il faut opérer le plus rapidement possible, idéalement dans les jours suivant le diagnostic, pour préserver la vision.
4. Vais-je retrouver ma vision normale après l’opération ?
Si la macula n’était pas décollée, les chances de récupération sont très bonnes. Sinon, la vision peut rester altérée malgré la réapplication de la rétine.
5. Peut-on avoir un décollement de rétine dans les deux yeux ?
Oui, surtout chez les patients myopes ou avec prédisposition génétique. C’est pourquoi un suivi régulier est essentiel.
Vous n’avez pas trouvé la réponse à votre question ?
Utilisez l’espace Commentaires ci-dessous pour poser votre question.
Nous prendrons le temps de vous répondre directement, et votre demande pourra aussi être utile à d’autres patients.

0 commentaires